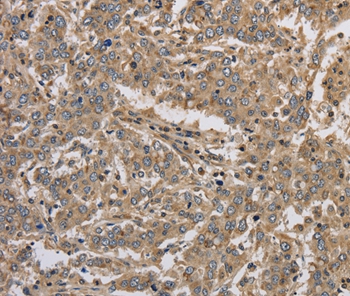
Anti-KCNMB3 Antibody

BK Beta3a Antibody (OASE00178)
OASE00178
ApplicationsImmunoFluorescence, ImmunoPrecipitation, Western Blot, ImmunoCytoChemistry, ImmunoHistoChemistry, Other Application
Product group Antibodies
TargetKCNMB3
Overview
- SupplierAviva Systems Biology
- Product NameBK Beta3a Antibody (OASE00178)
- Delivery Days Customer23
- ApplicationsImmunoFluorescence, ImmunoPrecipitation, Western Blot, ImmunoCytoChemistry, ImmunoHistoChemistry, Other Application
- CertificationResearch Use Only
- ClonalityMonoclonal
- Clone IDS40B-18
- Concentration1 mg/ml
- ConjugateUnconjugated
- Gene ID27094
- Target nameKCNMB3
- Target descriptionpotassium calcium-activated channel subfamily M regulatory beta subunit 3
- Target synonymsBKBETA3, HBETA3, K(VCA)BETA-3, KCNMB2, KCNMBL, SLO-BETA-3, SLOBETA3, calcium-activated potassium channel subunit beta-3, BK channel beta subunit 3, BK channel subunit beta-3, MaxiK channel beta-subunit 3, big potassium channel beta subunit 3, calcium-activated potassium channel regulatory subunit, calcium-activated potassium channel, subfamily M subunit beta-3, charybdotoxin receptor subunit beta-3, large conductance, voltage and Ca2+ activated potassium channel Maxi K beta 3 subunit, maxi K channel subunit beta-3, potassium channel subfamily M regulatory beta subunit 3, potassium large conductance calcium-activated channel, subfamily M beta member 3
- HostMouse
- IsotypeIgG1
- Scientific DescriptionBK channels contribute to electrical impulses, proper signal transmission of information and regulation of neurotransmitter release (1). A gain of function mutation in the pore-forming alpha subunit of the BK channel was linked to human neurological diseases. Findings suggest that the distribution of the beta subunits in the brain can modulate the BK channels to contribute to the pathophysiology of epilepsy and dyskinesia (2). This has major implications on other physiological processes in tissues other than the brain.
- Storage Instruction-20°C
- UNSPSC12352203